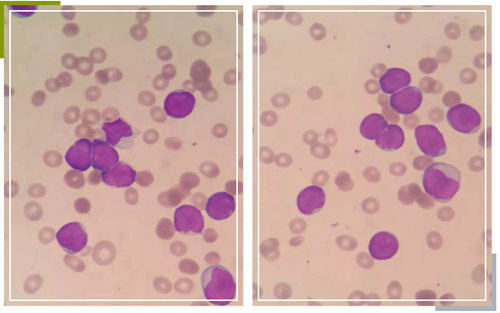

追本溯源,做一个善于思考的检验人--对临床肝功能障碍患者肝功能指标的解读作者:湖北文理学院2018届医检班侯奥华审稿:枣阳市第一人民医院(湖北文理学院附属枣阳医院)王裔雄11月份,接近上半年实习的尾声,我轮转
Àŵ൨ւ348
一例血小板减少的诊断浮星患者孙某,女,55岁,因“反复头晕7+年,再发加重10+天”门诊入院。查体:T:37.3℃,P:75次/分,R:20次/分钟,BP:90/60mmHg,神清,慢性病容,贫血貌,四肢可见瘀点、瘀斑,巩膜苍白,颈软
Àŵվ
这张报告吹了哨浮星 临床送检淋巴细胞免疫分析量不多,这天收到几个标本,其中之一检测结果如图所示:尽管在检测结果中患者NK细胞、B细胞、CD3细胞、CD4细胞、CD8细胞看似在参考范围内,但我们注意到患者CD4/CD8比值
工作中少些星空,但不能缺少发现之美
钙卫蛋白,是一种杂合的钙结合蛋白,作为中性粒细胞的更新标志物,可随肠道粘膜炎症等疾病而出现不同程度的增高,那么它的增高有哪些临床意义呢,检测方法,结构特性,分布情况,方法学评价是我们有待了解的内容。
血常规血小板与常规凝血四项的云思考罗宇成 宜昌市中心人民医院检验科前些天偶然被问到血常规血小板计数与常规凝血结果是否有联系,我当时脱口而出,常规凝血四项检测的是乏血小板血浆所以当然是没有什么联系啦。回